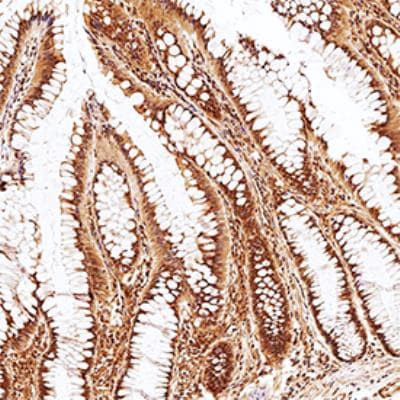
PLD2 Antibody in Immunohistochemistry (Paraffin) (IHC (P))

Search
Invitrogen
PLD2 Polyclonal Antibody
{{$productOrderCtrl.translations['antibody.pdp.commerceCard.promotion.promotions']}}
{{$productOrderCtrl.translations['antibody.pdp.commerceCard.promotion.viewpromo']}}
{{$productOrderCtrl.translations['antibody.pdp.commerceCard.promotion.promocode']}}: {{promo.promoCode}} {{promo.promoTitle}} {{promo.promoDescription}}. {{$productOrderCtrl.translations['antibody.pdp.commerceCard.promotion.learnmore']}}
图: 1 / 1
PLD2 Antibody (PA5-23335) in IHC (P)

产品信息
PA5-23335
种属反应
宿主/亚型
分类
类型
抗原
偶联物
形式
浓度
保存液
内含物
保存条件
运输条件
RRID
产品详细信息
Immunogen displays the following percentage of sequence identity for non-tested species: rhesus maque (81%).
靶标信息
PLD2 is a peripheral membrane protein belonging to phospholipase D family with a PH domain, two PLD phosphodiesterase domains and a PX (phox homology) domain that plays a regulatory rather than catalytic role. PLD2 catalyzes the hydrolysis of phosphatidylcholine (PC) to produce phosphatidic acid and choline. PLD2 may function in regulated secretion, signal-induced cytoskeletal regulation and/or endocytosis, transcriptional regulation, and cell cycle control. It is usually stimulated by phosphatidylinositol 4,5-bisphosphate (PIP2) and activated by the ADP-ribosylation factor-1 (ARF-1). PLD2 is activated by agonist stimulation of both tyrosine kinase and G protein-coupled receptors and is also known to interact with EGFR and PIP5K1A. PLD2, localized to plasma membrane caveolae, is ubiquitously expressed in most tissues.
仅用于科研。不用于诊断过程。未经明确授权不得转售。
篇参考文献 (0)
生物信息学
蛋白别名: Choline phosphatase 2; Phosphatidylcholine-hydrolyzing phospholipase D2; Phospholipase D2; PLD 2; PLD1C; splice variant hPLD2a; splice variant hPLD2b; unnamed protein product
基因别名: PLD1C; PLD2
UniProt ID: (Human) O14939
Entrez Gene ID: (Human) 5338